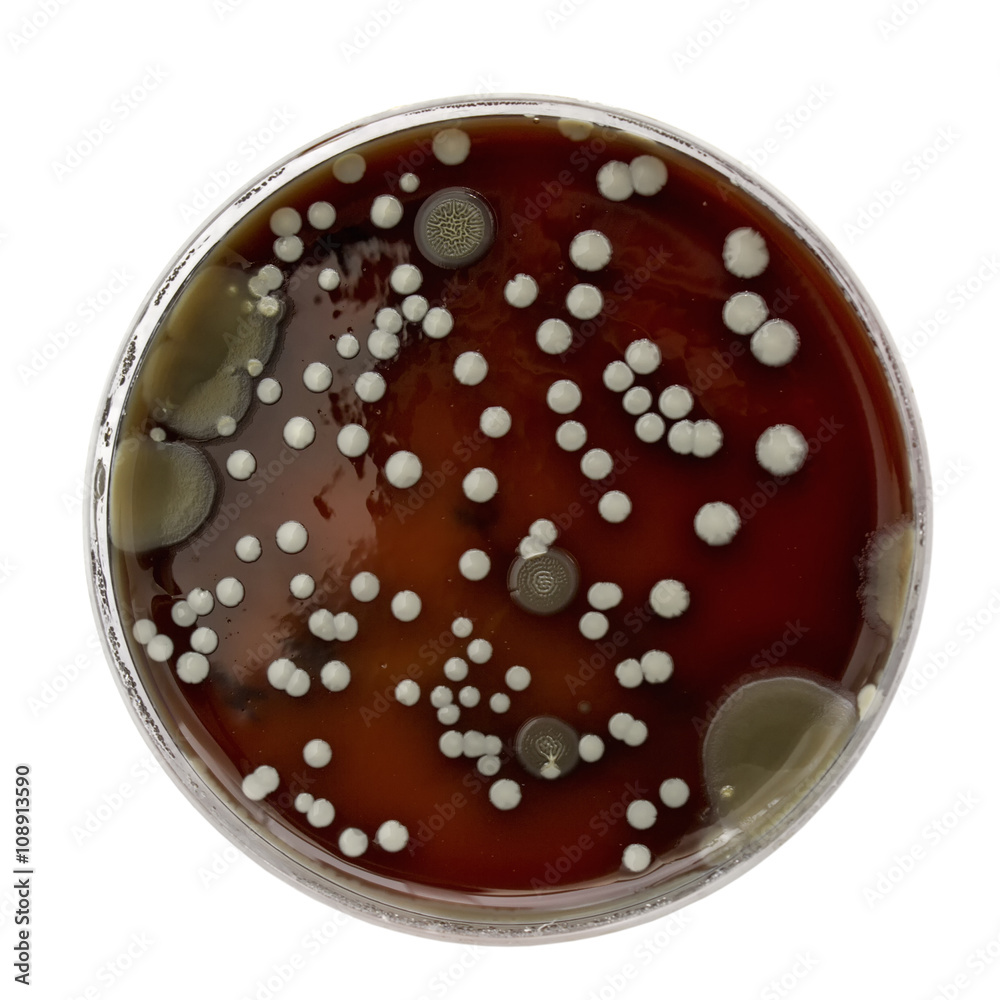

Научные фотографии колоний бактерий в чашке Петри

/imgs/2019/08/05/10/3492357/7b1dee9554dc837c5c5584399a21ce248859d88e.jpg)




































































































Раздел: Другие животные